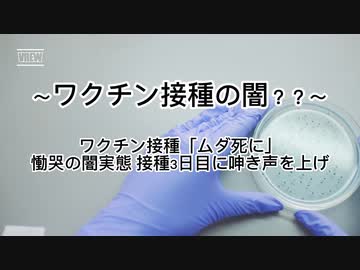
コロナワクチン闇？？ワクチン接種「ムダ死に」慟哭の闇実態 接種3日目に呻き声を上げ

再生
-
コメント
-
マイリスト
-
いいね
-
ニコラン的プロフィール
週刊ランキング履歴
| 番号 | 総合順位 | ポイント | ジャンル順位 | カテゴリ | 再生順位 | 再生数 | コメント順位 | コメント数 | マイリスト順位 | マイリスト数 | いいね順位 | いいね数 |
|---|---|---|---|---|---|---|---|---|---|---|---|---|
| 815 | 2700位 | 4,039 | 152位 | 社会・政治・時事 | 2633位 | 2,813 | 512位 | 426 | 12473位 | 0 | 2140位 | 80 |